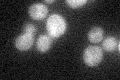
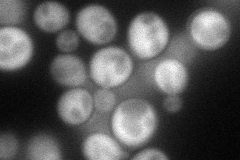
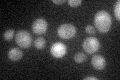

View description
Xylulokinase, converts D-xylulose and ATP to xylulose 5-phosphate and ADP; rate limiting step in fermentation of xylulose; required for xylose fermentation by recombinant S. cerevisiae strains
Localization:
Intensity:
Fold change:
Significance:
-
C’ GFP library in SD
cytosol29.61 -
N' NOP1pr-GFP in SD
cytosol82.6321 -
N' TEF2pr-mCherry in SD

cytosol294.695 -
N' NATIVEpr-GFP in SD

below threshold18.0356 -
N' TEF2pr-VC and Cyto-VN in SD

cytosol51.5951 -
C’ GFP library in SD+DTT

cytosol31.291.05No -
C’ GFP library in SD+H2O2

cytosol29.821No -
C’ GFP library in Starvation Media
cytosol39.141.32No -
C’ GFP library on the background of Pup2-DaMP

cytosol -
C’ GFP library on the background of CCT mutant

cytosol33.1191.11825No
